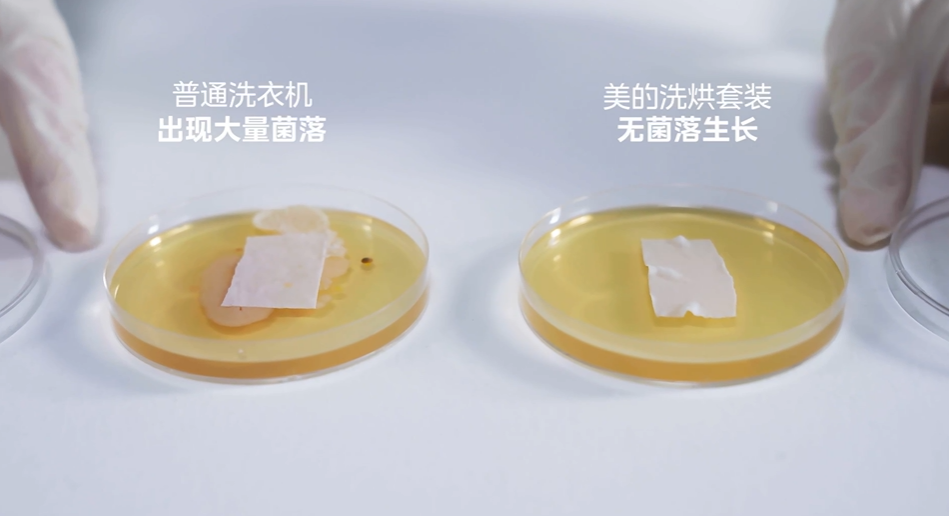

近年来,新型智能家电层出不穷,与我们生活愈发紧密联系。然而越来越多的厂商都在参数上「试比高」,最终陷入「卷参数」怪圈,从而导致消费者对产品的实际需求和使用体验产生困扰。
其实抛开产品参数,用户购置全屋家电的本质需求,仍然是:健康、高效、稳定。
而美的作为国内知名的家电品牌,一直都很注重科技创新和用户体验的提升,尤其在洞察到用户对厨居生活痛点及品质需求后,美的推出了全新的科技战略——「人感科技」,以及一系列美的人感科技新品。
借助「人感科技」,美的把家电从简单的工具升华为情感载体,让家电产品更加贴合人的需求,为我们生活带来更多便利和温暖。
例如在美的眼里,冰箱不仅要能长时间地保存食材的新鲜,更要保证每一口食物在你口中都具有鲜美滋味;空调不仅是调节室内温度,更要能关心每一位家庭成员的体感舒适度......
都说实践出真知,美的人感科技是不是炫技?相关产品究竟有何实力?
为了得到答案,我们对六款美的人感科技产品展开测评,下面就一起来看看!
近些年,极端天气困扰着空调产品的运行,就连用户的基础冷热需求都难以保障。而美的领航者III中央空调,通过对外机的多处技术升级,最终实现最高58℃的超高温强劲制冷、最低-25℃低温制热不停摆。
这种能力的背后,是美的独创的连续喷气增焓技术,高耐压聚能结构及热效率传感专利算法等,使得美的领航者III中央空调可在极限低温状态下,保证制热量和制热效率。
即便在温度为-25℃的冷库中,空调依旧稳定制热。
美的领航者III中央空调还通过优化外机风路通道、主板强热布局、液冷散热系统等技术,也保证了在超高温环境中的制冷优势。
即使58℃超高温环境下,也能强劲制冷。
优异的产品力,离不开技术加持,美的领航者III中央空调,能适应更多样的外机环境,为所有家庭提供空气保障!
破壁机中高速旋转的刀片,可深入至食材细胞壁反复切割,让食物中的营养物质充分地释放出来。
但转速越高、粉碎性能越好、饮品口感越丝滑,噪声也随之增加。
美的安睡小魔方破壁机创新性地将杯体和电机设计成悬浮结构,从声源处抑制工作噪声溢出,巧妙解决高粉碎性能与低工作噪声的难题!
我们用美的安睡小魔方和普通破壁机,依次进行了“噪声测试”和“豆浆过筛测试”。
在噪声测试中,普通破壁机增加噪声约为45分贝左右;美的安睡小魔方增加噪声约为23分贝左右。这样一对比,美的静音效果确实显著。
而豆浆过筛测试中,美的安睡小魔方打出来的豆浆基本无渣,顺利完成过滤;而普通破壁机仍有明显豆渣残留,无法完全过滤。可见,美的破壁机研磨精度更高。
在两轮测试中,美的安睡小魔方均完胜普通破壁机,性能和降噪完美结合,不愧是今年风很大的TOP单品!
微蒸烤炸一体机,算是多功能厨电的代表,它能微波、能蒸、能烤、炸,每个功能都不缩水。不过,现在市面上很多这类产品技术不成熟,导致使用体验差,尤其在烘烤时食物受热不均,是很多人吐槽的一环。
而美的知味感嵌入式微蒸烤炸一体机,创新设计风道,定制速热算法,巧妙解决了一体机温度波动大、升温不均等问题。
在专业热电偶测温仪显示下,一体机内上下层和四角等处温差均不超过2℃,控温精准。
对健康生活的人来说,“蒸”是日常首选烹饪方式。美的知味感嵌入式微蒸烤炸一体机搭载「杯水鲜蒸」技术,30秒出蒸汽,蒸汽能续航120分钟,同样是蒸压缩毛巾,美的一体机明显表现优于普通蒸烤箱,说明其蒸汽利用率更高、腔内积水少、续航能力强。
即使是非常讲究火候和煲汤手法的“老火靓汤”,美的一体机也能一键get,非常不错。
“民以食为天”,除了均衡搭配饮食外,其实食材新鲜度也很重要。美的冰箱研发的“微晶一周鲜”技术,通过双层冰点控温,让食材保持在微晶而不结冰的状态,最大化保留食材的口感与新鲜程度。
个人实测,牛排放入微晶抽屉一周,肉质依旧色泽鲜红,保持很好的新鲜度。美的微晶一周鲜存放的牛排,汁液流出少;而普通冰箱冷冻后的牛排,肉眼可见有大量血水。由此可见,美的微晶冰箱微晶保鲜能力一流。
冰箱内难免放置生熟食品,或带有包装的食品,这样一来外包装袋上处于休眠状态的细菌也就进入到了冰箱中。而美的微晶口感保鲜冰箱搭载的“脉冲净化”技术,能做到三分钟穿透包装袋,给食材快速杀菌。
我们拿和细菌结构相似的单细胞生物草履虫,做了一个脉冲杀菌实验,最后证实美的冰箱的脉冲净化,确实具有可穿透包装袋的除菌效果。以后,再也不用担心食材杀菌问题。
不得不说,美的让冰箱除菌率达99.999%,再次划时代提升!
普通用户对洗烘套装的期待,一是洗得干净,最好能除菌;二是烘得彻底,烘完就能穿。
在清洁衣物方面,美的元气洗烘套装洗涤时全程动态活水循环,充分溶解洗涤剂并扩大与衣物的接触面积,实现1.1高洗净比。实测重度污染也不怕,美的元气洗烘套装能将污染过后的布块,完全恢复到未污染时的干净状态。
美的元气洗烘套装在洗衣的同时,还能高效除菌,其搭载红蓝元气棒,蓝棒可以除菌除屑,让衣物更加洁净亲肤;红棒则是通过阻垢因子来软化水质,降低水垢的产生,保持衣物的柔顺。
在清洗时,进入洗衣机的水会先流经蓝棒再注入内筒,自来水会变成除菌水,让衣服实现无菌。经过测试,美的洗烘套装除菌水平完胜普通洗衣机,能做到真正的洗净。
先洗净后烘干,美的元气洗烘套装还搭载混动烘干系统,大四件套也能快速烘干,且烘干后的含水量仅为-1.9%,在专业热感仪检测下,依旧显示烘干均匀。
整体来看,美的元气洗烘套装完全可以满足我们日常生活中,对于衣物的清洁和护理需求。
众所周知,普通电热水器常年使用后不定期清理,内胆中会沉积大量水垢铁锈、死水等,造成沐浴水质变差。为解决该痛点,美的活水芯电热水器XQ5应用专利Tech活水技术,能有效完成内胆排污,通过一警二排三冲洗后的内胆能达到0渣0垢0死水,让你安心洗澡每一天。
当然,活水的关键在于“活”,定期排污换新水质才能时刻保持干净。XQ5为了能提供健康沐浴好水,在Tech活水技术基础上,搭配了养肤级活水芯,从源头净化水质。养肤级活水芯能实现98.8%的有效除氯,减少余氯对头皮毛孔的伤害。我们也做了一个“除余氯”小实验,结果显示,经美的XQ5电热水器流出的水,滴入余氯显色剂,无颜色变化,证明水中无余氯残留。
美的活水芯电热水器XQ5,内置锶芯,释放锶元素矿化水质。长时间使用富锶水洗浴,能提升肌肤的活力,缓解肌肤敏感。在我们的测试下,自来水经由美的热水器流出后,呈现出了与富锶矿泉水一样的检测效果。
都说好水养好人,如今美的活水芯电热水器通过科技的力量,让普通用户也能用上温泉好水,活水洗出健康澡。
通过这些产品测评,我们能感受到美的集团始终致力于给用户带来美好的生活,从客厅厨房、再到卫浴卧室,于细节处洞察用户在家电中的使用习惯,始终把人的感受放在科技之前。美的人感科技,即是让家电回归本质,也是未来智能家电行业的发展方向。
如果你没有体验过「人感科技」智能家电,那么你永远不会了解,智能化升级带来的愉悦感,这种对比才能真正显示出智能家电真正的价值,它会像智能汽车一样,带来旦用难回的感受。